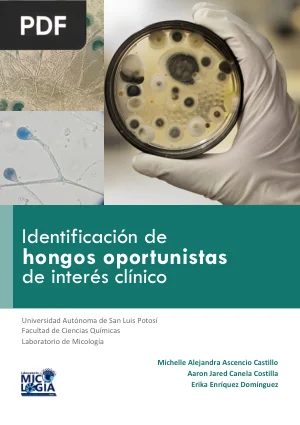
Identificación de hongos oportunistas de interés clínico

20 Libros de Hongos ¡Gratis! [PDF]
por InfoLibros

Descubre el fascinante reino de los hongos con nuestra amplia colección de libros gratis en PDF.
Los hongos son organismos fascinantes que desempeñan un papel crucial en la naturaleza y en nuestras vidas. Explora su diversidad, su papel en el ecosistema y su potencial medicinal a través de nuestros libros especializados.
Te invitamos a explorar nuestra página y descubrir la gran variedad de libros disponibles sobre el tema de los hongos. Desde guías de identificación hasta manuales de cultivo, hay algo para satisfacer la curiosidad de todos.
Sin necesidad de registro, puedes ampliar tus conocimientos sobre los hongos y disfrutar de una cultura de aprendizaje accesible para todos.
No pierdas más tiempo y comienza tu descarga de libros de hongos gratis ahora mismo. Sumérgete en el fascinante mundo de los hongos con solo unos clics y descubre su increíble diversidad y su importancia en nuestro entorno.
Descargá la colección completa de libros de Hongos
Todos los libros de esta página en un solo archivo ZIP, sin descargarlos uno por uno.
Te llevamos a accounts.google.com para completar el ingreso.
Solo email y nombre · Nunca enviamos spam
Descargá la colección completa de libros de Hongos
Todos los libros de esta página en un solo archivo ZIP, sin descargarlos uno por uno.
Descarga directa · Un solo archivo ZIP
Descarga iniciada. Buscá el ZIP en tu carpeta de descargas.
Libros de Hongos
Libros de Hongos comestibles
Libros de Cultivo de Hongos
Libros de Micología
- #1
Micología
Y bien, esta fue nuestra colección de libros de Hongos en formato PDF. Esperamos que te haya gustado y encuentres tu próximo libro!
Si te fue útil este listado no olvides compartirlo en tus principales redes sociales. Recuerda que "Compartir es Construir".
¿Quieres más libros de Biología en formato PDF?